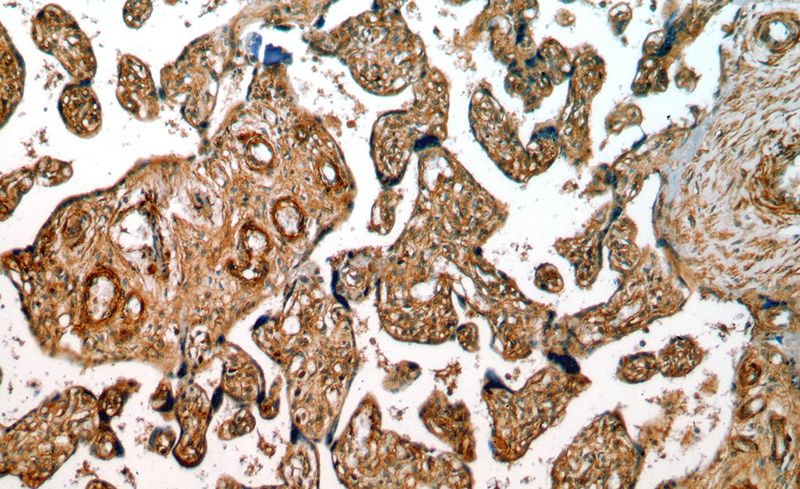
Immunohistochemical of paraffin-embedded human placenta using Catalog No:111116(GPR161 antibody) at dilution of 1:50 (under 10x lens)

-
Product Name
GPR161 antibody
- Documents
-
Description
GPR161 Rabbit Polyclonal antibody. Positive WB detected in HeLa cells, HEK-293 cells. Positive IHC detected in human placenta tissue. Observed molecular weight by Western-blot: 70 kDa
-
Tested applications
ELISA, WB, IHC
-
Species reactivity
Human,Mouse,Rat; other species not tested.
-
Alternative names
FLJ33952 antibody; G protein coupled receptor 161 antibody; G protein coupled receptor RE2 antibody; GPR161 antibody; RE2 antibody
-
Isotype
Rabbit IgG
-
Preparation
This antibody was obtained by immunization of GPR161 recombinant protein (Accession Number: NM_001375883). Purification method: Antigen affinity purified.
-
Clonality
Polyclonal
-
Formulation
PBS with 0.02% sodium azide and 50% glycerol pH 7.3.
-
Storage instructions
Store at -20℃. DO NOT ALIQUOT
-
Applications
Recommended Dilution:
WB: 1:500-1:5000
IHC: 1:20-1:200
-
Validations

HeLa cells were subjected to SDS PAGE followed by western blot with Catalog No:111116(GPR161 antibody) at dilution of 1:500
Immunohistochemical of paraffin-embedded human placenta using Catalog No:111116(GPR161 antibody) at dilution of 1:50 (under 10x lens)

Immunohistochemical of paraffin-embedded human placenta using Catalog No:111116(GPR161 antibody) at dilution of 1:50 (under 40x lens)
-
Background
GPR161 (also known as RE2) is an orphan G protein-coupled receptor and plays important roles in the Hh pathway. In the absence of Hh signals, GPR161 localizes to primary cilia and keeps the downstream GLI transcription factors in their repressor forms (PMID: 26305592). Ciliary localization of GPR161 requires TULP3 and the IFT-A complex. In presence of SHH, GPR161 is removed from primary cilia and is internalized into recycling endosomes, preventing its activity and allowing activation of the Shh signaling.
-
References
- Garcia-Gonzalo FR, Phua SC, Roberson EC. Phosphoinositides Regulate Ciliary Protein Trafficking to Modulate Hedgehog Signaling. Developmental cell. 34(4):400-9. 2015.
- Yee LE, Garcia-Gonzalo FR, Bowie RV. Conserved Genetic Interactions between Ciliopathy Complexes Cooperatively Support Ciliogenesis and Ciliary Signaling. PLoS genetics. 11(11):e1005627. 2015.
Related Products / Services
Please note: All products are "FOR RESEARCH USE ONLY AND ARE NOT INTENDED FOR DIAGNOSTIC OR THERAPEUTIC USE"
